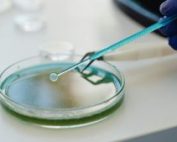

Qué servicios podemos ofrecerte.
Contáctanos hoy para una consulta inicial:
Si estás enfrentando problemas legales en las áreas de derecho civil o laboral, estamos aquí para brindarte la representación sólida que mereces.
Nuestra dedicación a tu caso y nuestro compromiso con la justicia nos convierten en la elección adecuada para tus necesidades legales.
Tu tranquilidad y protección son nuestra prioridad absoluta.
Por qué elegirnos:
Noticias
Amparo a madre por no investigarse suficientemente la muerte sospechosa de su hijo
La Sala Segunda del Tribunal Constitucional, en sentencia cuyo ponente ha sido el magistrado Ramón Sáez Valcárcel, ha estimado por unanimidad el recurso de amparo presentado por la madre de una persona con discapacidad intelectual,[...]
El Gobierno aprueba un real decreto para garantizar un alto nivel de protección en productos sanitarios de diagnóstico ‘in vitro’
[[{"value":" La nueva ley también establece la obligación de recabar el consentimiento expreso de las personas objeto de una prueba genética El Consejo de Ministros ha aprobado este martes un nuevo Real Decreto (RD) de[...]
La abogacía de familia se reúne esta semana en Madrid
El Ilustre Colegio de la Abogacía de Madrid será esta semana el epicentro del debate jurídico y profesional sobre los grandes retos del Derecho de Familia y Sucesiones, con la celebración, los días 23 y[...]
Financiado por la Unión Europea – NextGenerationEU.